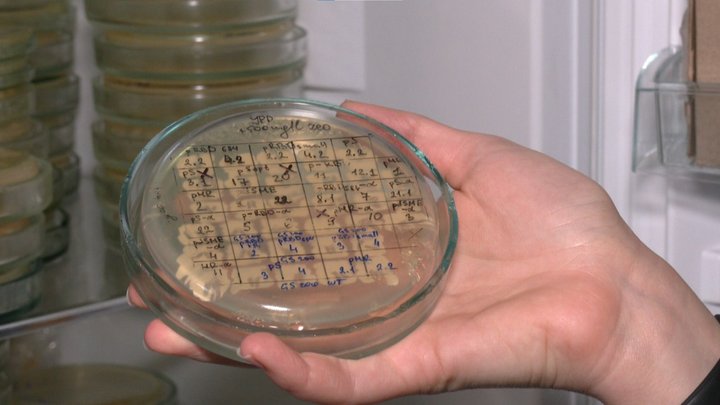

Украинские ученые в состоянии произвести вакцину от коронавируса, - Шкарлет
Сегодняшняя украинская наука в состоянии сделать вакцину от коронавируса. Львовские ученые ближе всего к этому. Об этом заявил министр образования Украины Сергей Шкарлет. gogetnews.info »